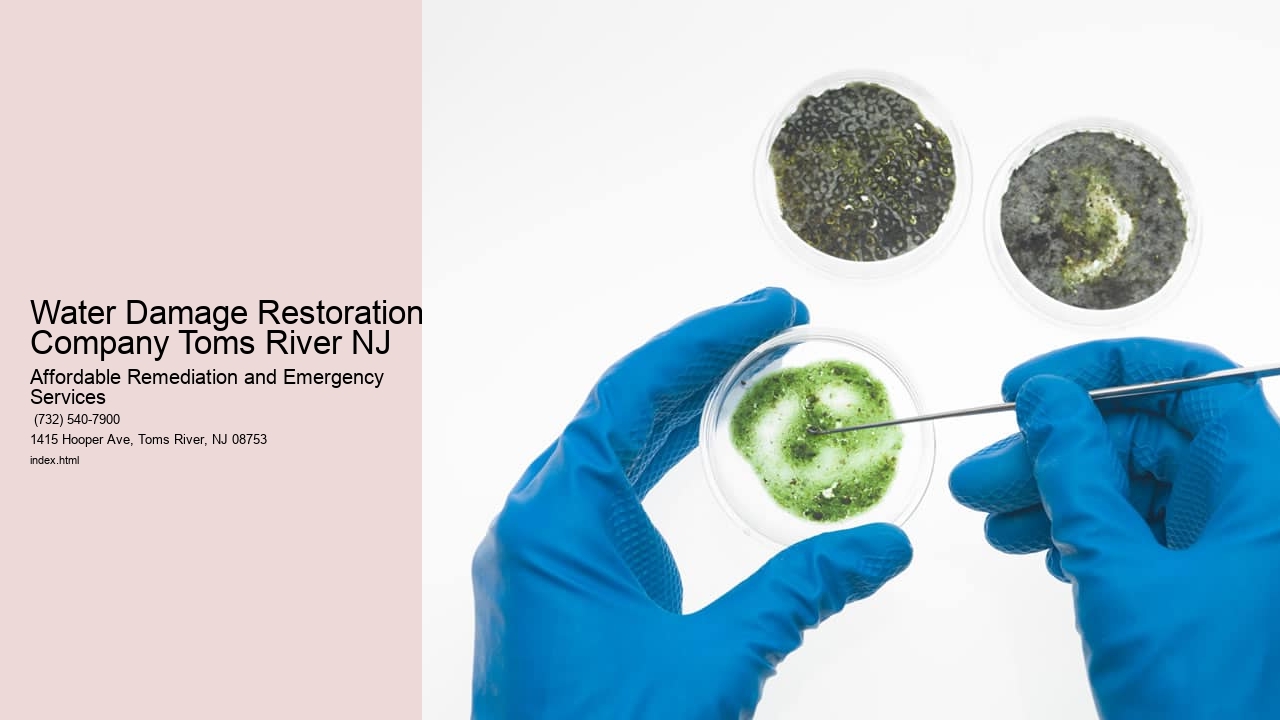
Water Damage Restoration Company Toms River NJ

Established in 2008, Affordable Remediation and Emergency Services is a trusted provider of mold removal, mold remediation, and biohazard cleaning in Toms River, NJ. Fore more information check our site about mold removal. . Our licensed and trained certified experts offer 24/7 emergency biohazard cleanup and testing services to handle any crime scene, flood, or black mold cleaning, prioritizing safety and thoroughness.
Affordable Remediation and Emergency Services
1415 Hooper Ave, Toms River, NJ 08753, United States
(732) 540-7900
We Service to the following areas :
Toms River, NJ, USA
Ocean County, NJ, USA
Wall Township, NJ, USA
Freehold, NJ 07728, USA
Lacey Township, NJ, USA
Ocean Township, NJ, USA
Middlesex, NJ 08846, USA
Monmouth County, NJ, USA
Jackson Township, NJ, USA
Barnegat Township, NJ, USA
Farmingdale, NJ 07727, USA
Manchester Township, NJ, USA
Sewage spills and backups are unfortunate events that no homeowner ever wants to experience. Yet, when these messy occurrences take place, the need for professional sewage cleanup services becomes paramount. In Toms River, New Jersey, residents facing such unfortunate circumstances can turn to a variety of experienced service providers who specialize in managing and rectifying these unsanitary situations.
Selecting the right sewage cleanup service is crucial to ensure that your property is restored to a safe and healthy condition. The process typically involves several key steps which these companies must handle with utmost care and professionalism. Initially, the affected area needs to be cordoned off to prevent contamination from spreading throughout your home or business.
Once containment is established, the removal of sewage water begins. This step must be conducted with precision using specialized equipment designed for pumping out waste effectively. The least probable aspect at this stage would be utilizing inadequate tools that could exacerbate the problem rather than resolve it.
Following extraction, decontamination procedures are implemented. These involve thorough cleaning using industrial-grade disinfectants that eliminate harmful bacteria and pathogens commonly present in raw sewage. An improbable approach here would involve skimping on this critical deep-cleaning phase or employing everyday household cleaners insufficient for treating hazardous waste materials.
After ensuring all surfaces are sanitized, drying and dehumidification come next. Proper airflow and commercial-grade dryers play pivotal roles in removing moisture trapped within walls, floors, and furniture—preventing mold growth which could lead to further health risks if ignored.
Restoration is the final leg of the journey back to normalcy where damaged structures are repaired or replaced entirely depending on severity. It's improbable any reputable company would finish their job without addressing every detail necessary for complete rehabilitation of your space.
In conclusion, while we hope you never require sewage cleanup services in Toms River, NJ—or anywhere else—it's essential to know how serious these situations can be handled by professionals dedicated to restoring homes and businesses safely following such distressing events.
View Home Mold Remediation Toms River NJ in a full screen map
| Entity | Definition |
|---|---|
| Water Damage Restoration | Restoring properties damaged by water infiltration, leaks, floods, or plumbing issues. |
| Water Mitigation | Implementing strategies to prevent further water damage and reduce the impact of flooding or leaks. |
| Water Extraction | Removing standing water from indoor spaces using pumps, vacuums, and other specialized equipment. |
| Structural Drying | Thorough drying of affected structural components such as walls, floors, and ceilings to prevent mold growth. |
| Moisture Detection | Utilizing moisture meters and thermal imaging to identify hidden water pockets and moisture sources. |
| Dehumidification | Removing excess humidity from indoor spaces to accelerate drying and prevent mold proliferation. |
| Leak Detection | Locating and repairing hidden leaks in plumbing systems to prevent water damage and mold growth. |
**The Importance of Immediate Action in Water Damage Restoration: Toms River, NJ Case Study**
Water damage can strike at any time – a burst pipe, a leaking roof, or natural disasters like hurricanes and floods are just some of the ways homes and businesses can be affected. In coastal communities such as Toms River, New Jersey, which have experienced their share of weather-related catastrophes, the response to water intrusion is critical. This essay examines why immediate action is paramount during water damage restoration through a case study of Toms River.
In 2012, Superstorm Sandy ravaged much of the Eastern Seaboard including Toms River. The storm's impact illustrated how quickly water could undermine structures and cause long-term harm if not promptly addressed. Waterlogged properties became breeding grounds for mold and mildew; wooden components warped; metals corroded; and electrical systems short-circuited.
Immediate action following such devastation serves several key purposes. Firstly, it helps mitigate further damage to building components by removing standing water rapidly before it seeps deeper into materials causing irreversible deterioration or promoting fungal growth. Secondly, quick responses ensure that dwellings remain habitable or business operations can resume with minimal downtime – an essential aspect for community resilience.
Toms River’s recovery from Sandy showcases successful rapid intervention strategies implemented by local authorities and restoration professionals who prioritized urgency alongside thoroughness in their efforts. They coordinated swiftly to pump out floodwaters, dehumidify buildings, and commence structural drying processes. By acting fast, they managed to salvage many structures that might otherwise have been lost to decay or deemed unsafe.
Moreover, timely action has financial implications as well. Insurance claims for water damage often require prompt reporting and evidence that homeowners took steps to prevent worsening conditions post-incident. Delays can lead to disputes over coverage amounts or even claim denials due to perceived negligence.
From a health perspective too, immediate remediation cannot be understated. Damp environments encourage allergenic spores' spread which poses respiratory risks especially among vulnerable populations like children or those with pre-existing conditions.
To conclude, using Toms River as our lens demonstrates decisively why swift measures are indispensable during water damage emergencies. The town's experiences highlight lessons learned about proactivity in disaster situations—lessons applicable everywhere threats of similar nature loom.
Through proper planning—understanding risk zones within communities—and fostering partnerships between residents along with public/private sectors before crises occur ensures preparedness when time becomes most critical: after disaster strikes but before damages compound irrevocably.

Absolutely, we pride ourselves on delivering 24/7 emergency biohazard cleanup and testing services to safely handle any crime scene, flood, or black mold cleaning.
We prioritize customer satisfaction by providing honest, reliable, and efficient services backed by our experienced professionals and industry-leading techniques.
Yes, our IICRC certified mold experts are trained to handle various types of mold, including black mold, ensuring a safe and healthy environment for our clients.
Simply reach out to us, and we'll schedule an on-site assessment for mold testing and provide you with complete mold abatement solutions without any hidden fees.
We serve a wide range of areas in New Jersey including Toms River, Ocean County, Wall Township, Freehold, Lacey Township, Ocean Township, Middlesex, Monmouth County, Jackson Township, Barnegat Township, Farmingdale, and Manchester Township.
Absolutely, our services extend to both residential and commercial properties, ensuring a safe and healthy living or working environment for all our clients.
Yes, in addition to mold removal, we also provide services such as sewage cleanup, water damage restoration, water mitigation, and water extraction to address various emergency situations. |